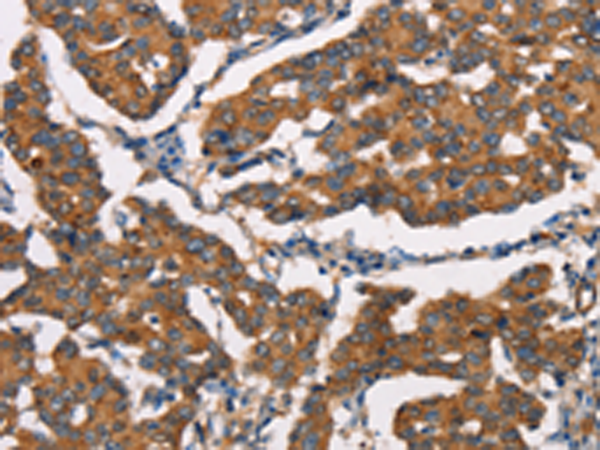

|
Background: |
This gene encodes a protein possessing an RNA helicase motif containing a DEXH box in its amino terminus and an RNA motif in the carboxy terminus. The encoded protein functions as a ribonuclease and is required by the RNA interference and small temporal RNA (stRNA) pathways to produce the active small RNA component that represses gene expression. Alternative splicing results in multiple transcript variants. |
|
Applications: |
ELISA, IHC |
|
Name of antibody: |
DICER1 |
|
Immunogen: |
Synthetic peptide of human DICER1 |
|
Full name: |
dicer 1, ribonuclease type III |
|
Synonyms: |
DCR1; MNG1; Dicer; HERNA; RMSE2 |
|
SwissProt: |
Q9UPY3 |
|
ELISA Recommended dilution: |
1000-2000 |
|
IHC positive control: |
Human breast cancer and Human gastric cancer |
|
IHC Recommend dilution: |
25-100 |
購物車
購物車 幫助
幫助
 021-54845833/15800441009
021-54845833/15800441009
